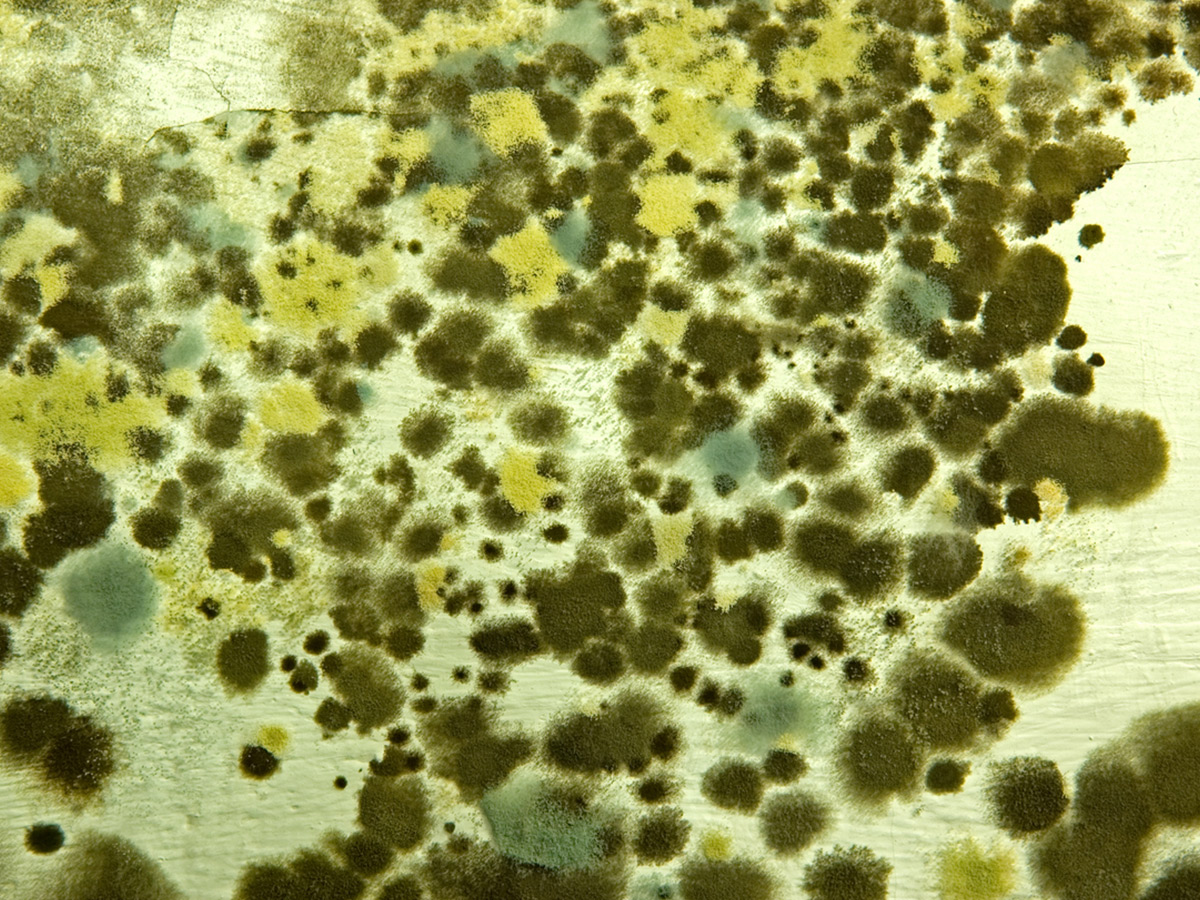

Articles
[seopress_breadcrumbs]
Collateral Benefits of Ultrasonic Cleaning
Part durability and consistency are key objectives for manufacturers of traffic and crosswalk signals and other technology that must stand the test of time in the elements. One such company is meeting these demanding requirements with its products while also realizing cost savings and decreasing its environmental impact. The July issue of Production Machining introduced […]
Benchtop Ultrasonic Cleaner
The Omegasonics OMG-1420BTD 16-gallon bench-top ultrasonic cleaner features a digital temperature controller and digital timer-controlled ultrasound that lets operators precisely control the bath temperature and the exact time the cavitation energy hits the parts being cleaned. The tank’s compact internal size (21’L x 15’W x12-1/4’ D) make it ideal for cleaning parts that don’t require […]
Coming Ultrasonically Clean
As a rule of thumb, buyers of ma-chined parts don’t want to see any particles or oily film on their merchandise. Therefore, most blue-prints specify parts must be clean and dry—but don’t indicate how that must be achieved or what level of cleanliness is required, noted Lou Tignac, owner and president of Van’s Manufacturing Inc. […]
Omegasonics Ultrasonic Cleaning Unit Enables Accurate Adjustments
This cleaner is designed to enable operators to accurately adjust both the bath temperature and the exact amount of time the cavitation energy hits the parts being cleaned. Omegasonics’ Model1420BTD ultrasonic cleaner is a bench-top unit designed to provide the operator with a high level of control. With a digital temperature controller and digital timer-controlled […]
Omegasonics’ Viking Series Designed for Precision Cleaning
The line is available with a dryer in two, three and four stages. Omegasonics’ Viking Series is a line of multi-stage ultrasonic cleaning stations designed for precision parts and components cleaning with multiple washes and rinses. The line is available with a dryer in two, three and four stages. All units are designed for maximum portability […]
A New Way to Clean Revolutionizes a French Fry Plant
Ultrasonic cleaning technology helps a Canadian frozen foods processor save on production costs. To produce frozen French fries, Cavendish Farms uses intricate machinery that requires regular cleaning and maintenance to decrease downtime and increase efficiency. In its New Annan potato processing plant on Canada’s Prince Edward Island, the process required to maintain its technology was […]
Tube fabricator uses ultrasonics for parts cleaning
The Fabricator/March 2007 Situation Many manufacturers, large and small, are now discovering a great labor, time and toxic-solvent saving device: the ultrasonic tank. For many manufacturers parts cleaning traditionally calls for dedicated labor and toxic solvents, which often require special handling and disposal. Tube fabricator Eaton Aerospace of Jackson, Mich., was no different. The company produces stainless […]
Ultrasonic Cleaning Saves Time, Money
PF Online/March 2007 – Ultrasonic Cleaning System Replaces Labor-Intensive Solvent Cleaning Eaton’s large ultrasonic system features 300-gal tanks for washing and rinsing, and up to 4000 W of ultrasonic power. Agitation in the rinse tank is via the action of the hoist. Parts cleaning in industrial settings-especially those with demanding quality requirements, such as in […]
Parts Cleaning Goes Ultrasonic
Tool Die & Stamping News/Jan-Feb 2007 Volume 35 #1 – Manufacturers replace laborious, time-consuming and toxic parts cleaning with “set it and forget it” ultrasonic tanks Many manufacturing concerns large and small are now discovering a great labor, time and toxic-solvent saving device: the ultrasonic tank. Parts cleaning in industrial machining and manufacturing has, traditionally, necessitated […]
Kaysun Keeps Clean with Parts Washer
Industrial Maintenance & Plant Operation/February 2007 Volume 68 #2 Plastic injection molding is a huge industry, constantly innovating to keep up with demand. Through heavy use, however, molds become contaminated with grease, hydraulic oil, rust, grime, carbon, aluminum shavings and material gassing, and many are still cleaned the old-fashioned way with labor-intensive hand scrubbing and […]
Streamline Your Mold Cleaning Process
Ultrasonics can help your shop reduce labor costs and product waste while boosting efficiency and product quality. Download Streamline Your Injection Mold Cleaning Process article. Plastic injection molding offers many benefits to the buying public. Lightweight durable plastics designed to enhance the American way of life. Injection molders benefit from a more diverse array of […]
Shop Sends Manual Labor Down the Tubes
American Machinist, May 2006 Download Shop Sends Manual Labor Down the Tubes PDF. Customers of Eaton Aerospace (www.aerospase.eaton.com) in Jackson, Mich., are quite fussy about how the tubing produced by the shop looks. The tubing goes into aircraft such as the Airbus 380, the F-22 Raptor and F-35 Joint Strike Fighter to convey air, oil, water and […]
Increasing Parts Cleaning Capacity by 300%
Reprinted from Process Cleaning Magazine. Download the Increasing Parts Cleaning Capacity by 300% PDF Omega Pro® ultrasonic parts washing system helps Renco Encoders operate at optimum levels. Maintaining efficient machine shop and parts finishing production is dependent on many factors. Even when SB VS SB operating at near optimum levels, throughput can be slowed by […]
Coming Clean on Washing Technologies
As the Gearing Industry moves away from solvents, new industrial washers get parts cleaner, improving product quality and production efficiency. The techniques for manufacturing gears and gear components do not differ dramatically from other industries. Precision cutting, grinding, polishing, and buffing are all part of the process. But manufacturing is not complete until the gear assemblies […]
Sound Waves and Parts Cleaning
From www.MPNmag.com May 2005 – Ultrasonic cleaners like these from Omegasonics, can save your dealership money over the long haul. How much time do your service personnel spend with industrial parts cleaning? Does one employee get to do all the dirty work, or does each technician clean whatever he or she is working on? Either […]
“Clean and Green”, with Jay Leno, as featured in Popular Mechanics magazine.
By Jay Leno – From Popular Mechanics Sept. 2004 Download “Clean and Green”, with Jay Leno, as featured in Popular Mechanics magazine. Aromatic Nose: A safe solvent doesn’t necessarily smell nice. If we all want to continue to have this car hobby that we all enjoy so much, we have to learn to police ourselves, or someone […]
What’s All The Noise About Ultrasonics?
Boat & Motor Dealer September/October 2003 Download What’s All The Noise About Ultrasonics? PDF. These high-tech cleaning systems can provide a less-toxic alternative to solvents. Omegasonics manufactures a complete line of ultrasonic cleaning equipment ranging from table top carburetor cleaners to large capacity floor models ideally suited for the marine industry. For more information, visit […]
Ultrasonic System Offers Quick, Non-Toxic Valve-Body Cleaning
By Len Gutman – From Transmission Digest. November 2002 Download the Transmission Digest article Cleaning transmission components in an ultrasonic machine is as simple as loading the parts into a washing basket, closing the lid and pushing a button. Charles Carr knows that properly cleaning transmission parts is absolutely mandatory for quality transmission rebuilding. Carr bought […]